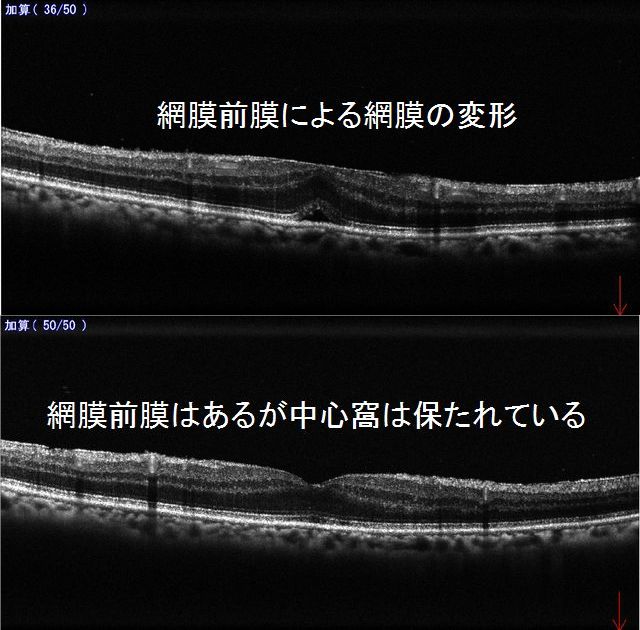

疾患の説明


網膜前膜とは・・・
  網膜前膜は黄斑前膜やERMとも呼ばれます。
  読んで字のごとく網膜の上にできる薄い膜状の病変です。
進行はきわめて緩やかな場合が多く、網膜裂孔からでた細胞などが原因の場合もありますが、多くは原因不明の特発性のものです。
進行は緩やかな場合が多く、これが原因で網膜に皺がよると、ものがゆがんで見えて視力が低下する原因になります。
薬では治療は不可能です。
膜があっても視力がよい場合がかなり多く、ある程度視力低下が起こる場合にのみ本人の希望があれば手術が行われます。
手術では硝子体手術で膜を直接、特別なピンセットでつまんでむしりとります。
むしりとった直後は視力が一時的に低下する場合がありますが、1ヶ月以内に術前と同様な視力またはそれ以上に回復する場合が多いです。
1ヶ月たっても改善しない場合でも半年くらいで改善することもあり、気を長く持ってもらう必要があります。
硝子体手術は基本的に入院が必要ですので、可能な施設(金沢大学附属病院や金沢医療センター、石川県立中央病院)へ紹介させていただいております。
当院でOCTによる評価が可能なので、術後のフォローアップはこちらでする場合も多いです

    網膜前膜のある眼底写真です、きらきらとした部分がそうです。
真ん中に穴が開いているように見えることから、偽黄斑円孔ともよばれます。
 黄斑前膜のOCT画像になります。
当院では網膜の断面を撮影するOCTを2021年に最新のもの(NIDEK製Mirante)に更新し、さまざまな網膜疾患の診断と、緑内障の評価に役立てております。
網膜前膜により網膜が牽引され、網膜に皺ができたり、網膜中心のくぼみが平坦に変形したりしています。